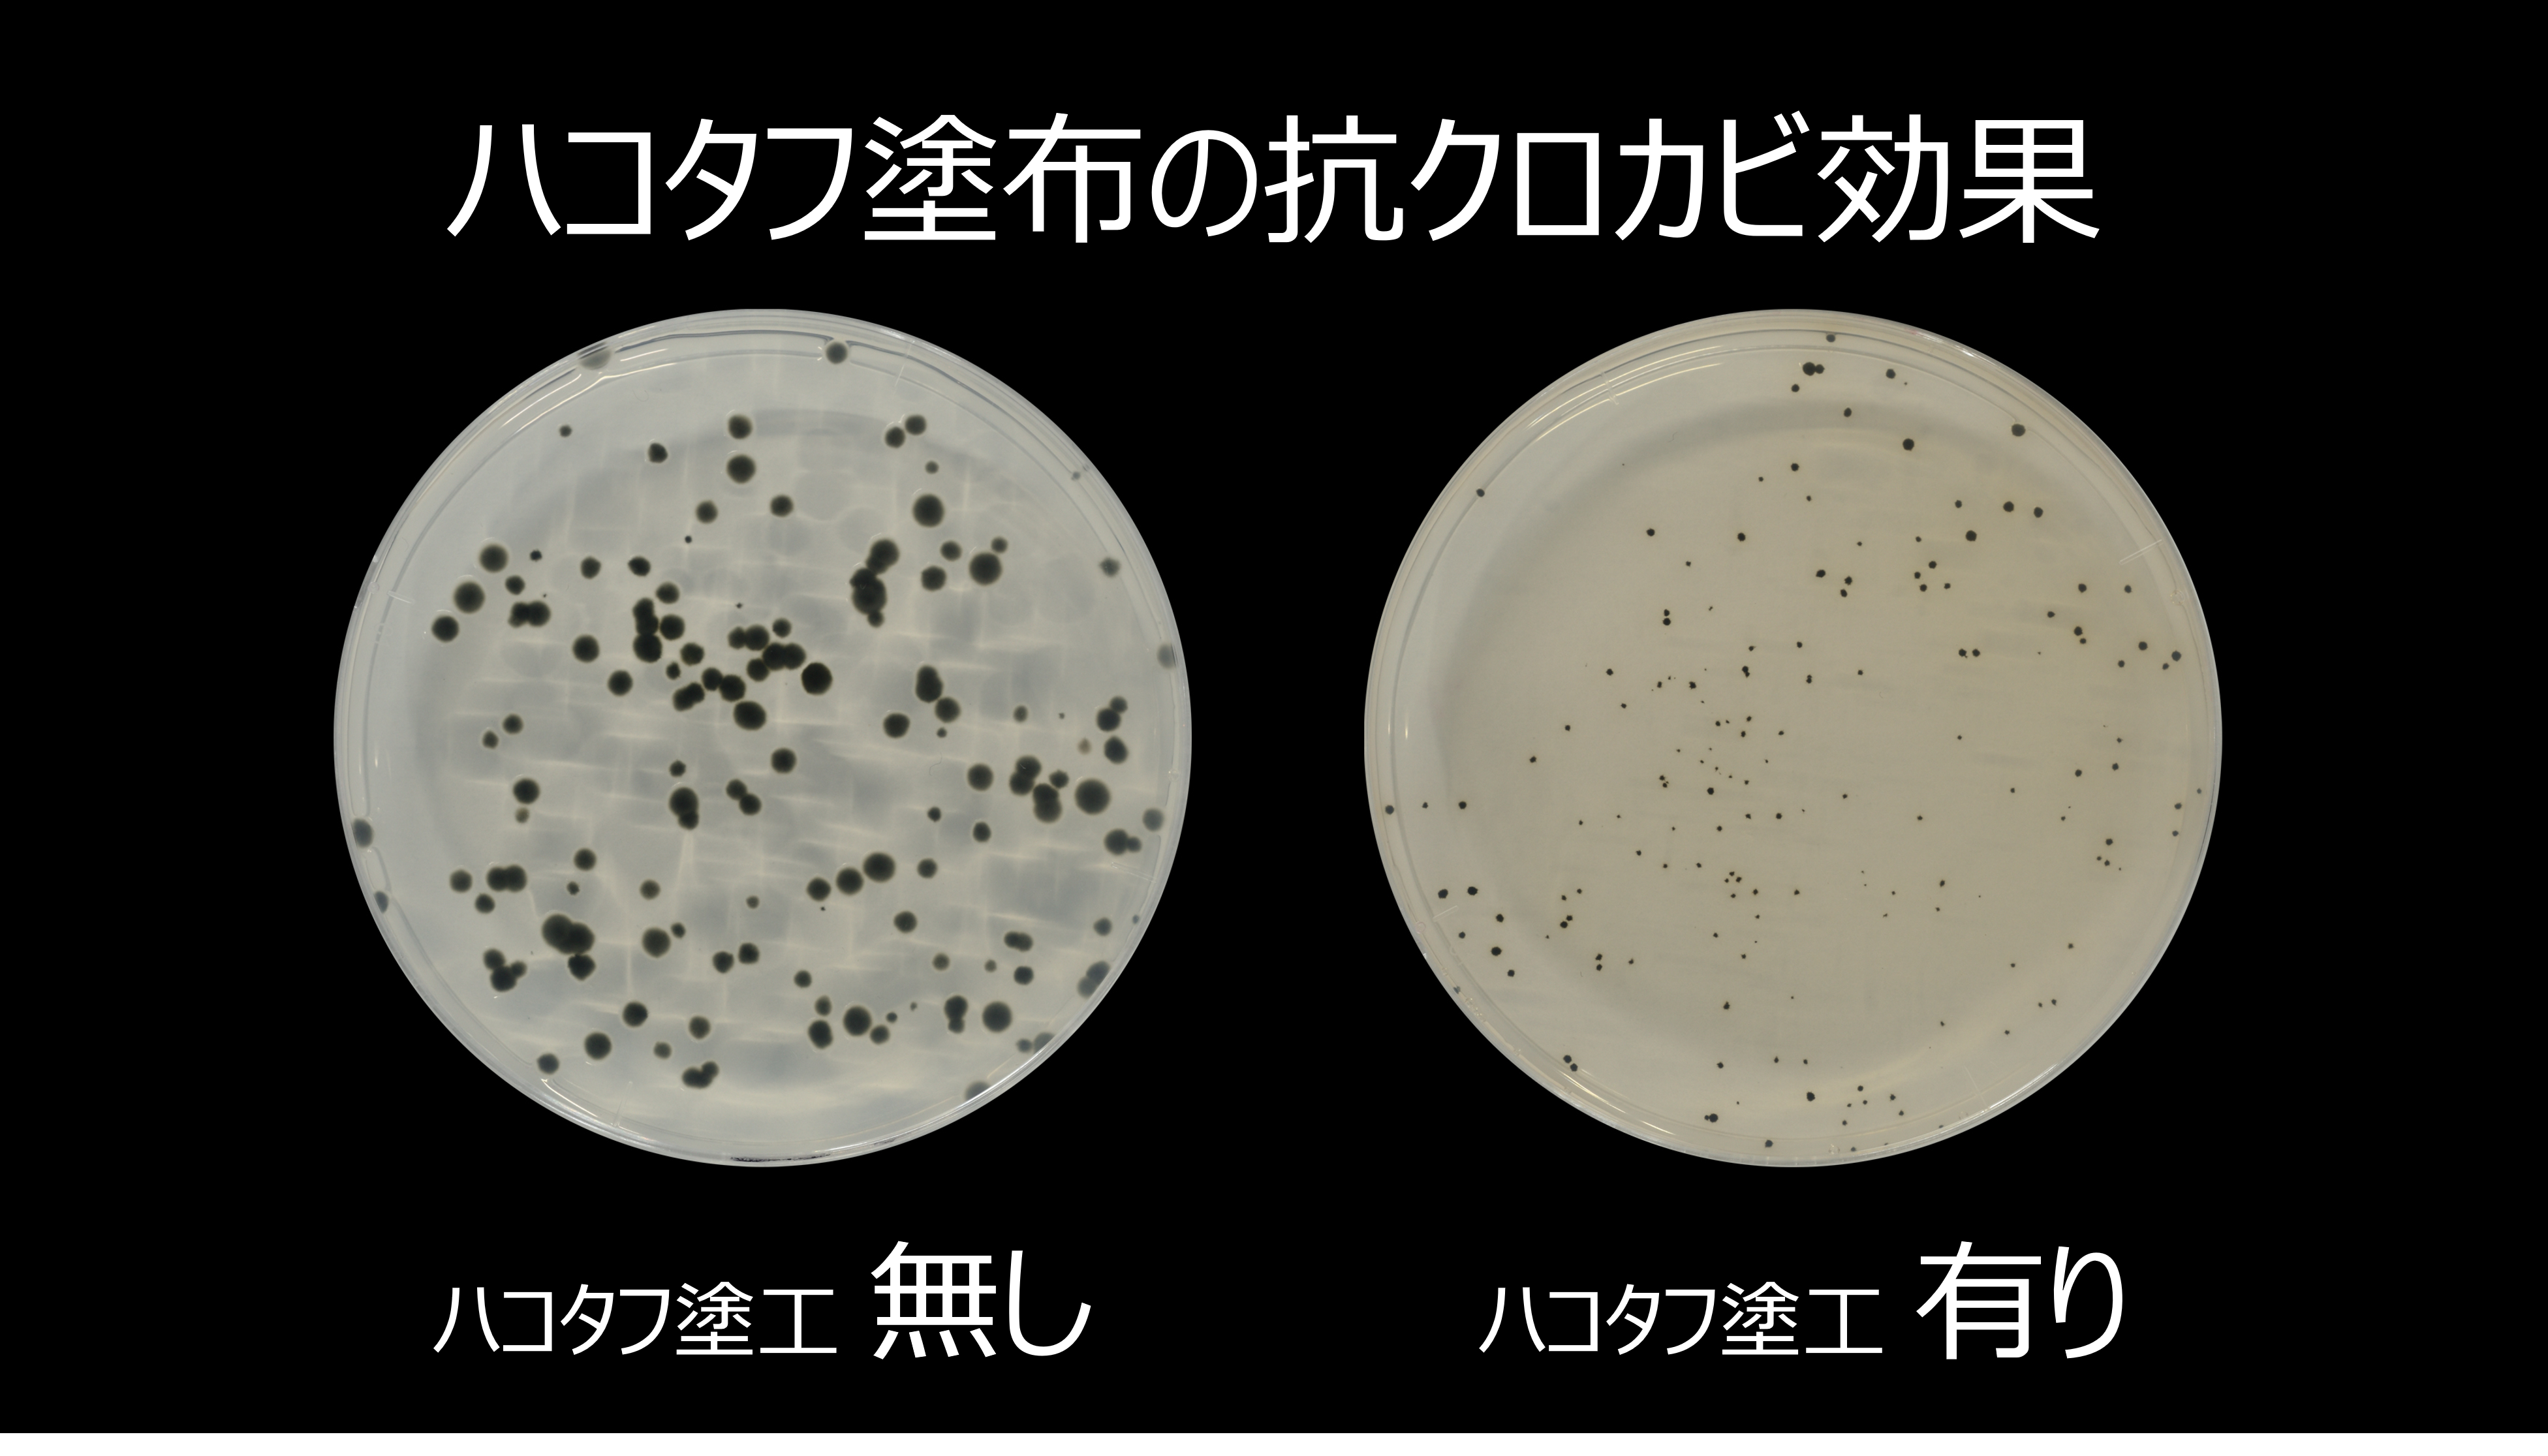

【法人限定】段ボールエンハンサー ハコタフ 14Kg
※本商品は法人・事業者様向け(BtoB)の商品です。
個人のお客様はご購入いただけませんのでご了承ください。
段ボールに“強さ”と“清潔感”をプラスする、新しい選択肢
段ボールエンハンサー「ハコタフ」は、一般的な段ボールに後から施工できる専用コーティング剤です。必要な場面で手軽に塗布でき、段ボールの扱いやすさや耐久性、衛生的な環境づくりをサポートします。避難所の段ボールベッドや間仕切り、家庭の収納箱など、幅広い用途で活用できるソリューションです。また、プラダン(プラスチック段ボール)や合成樹脂フィルムのラミネート加工とは異なり、段ボール本来のリサイクル性を損なわず、廃棄時の環境負荷を抑えられる点も特長です。
脱プラ・脱炭素の取り組みにも適した設計となっています。
【使用対象】
被災地で使用される段ボール製ベッド・間仕切りに加え、一般的な段ボール製品(収納箱・梱包材など)にもご利用いただけます。
【特徴】
● 強度サポート(社内試験で確認)
表面に薄い被膜を形成し、未加工の段ボールと比較して曲げ強度が約1.5倍となることを社内試験で確認しています。
※段ボールの種類や使用環境により結果は異なります。
● 水分による劣化を抑える撥水性
湿気や水滴が付着しやすい環境でも、段ボールの状態維持に役立つ撥水性を備えています。
● 空間中のカビに対する抑制効果(第三者試験で確認)
青森ヒバ由来成分「ヒノキチオール」を配合。
第三者機関による試験において、空間中のカビに対する抑制効果が確認されています。
香りとともに、清潔な環境づくりをサポートします。
※人体への効果を示すものではありません。
● 環境負荷に配慮した素材設計
天然由来成分を主体とした処方で、段ボールのリサイクル工程に影響しにくい設計です。
プラスチック素材を追加せずに性能を付与できるため、プラダンや樹脂ラミネート加工と比較して廃棄時の環境負荷を抑えられます。
● 多用途で使いやすい
避難所・家庭・業務用途など、強度と衛生管理が求められる幅広いシーンで活躍します。
【主成分】
低環境負荷樹脂、青森ヒバ抽出成分、天然脂肪酸、アルコール
【製造国】
製造国は日本で、厳格な品質管理の下で作られています。
【用途の紹介】
段ボール製品全般に使用できます。
避難所などでの現場施工に加え、災害に備えて事前に塗工しておくことも可能です。
ハコタフを塗布すると表面に被膜が形成され、社内試験では曲げ強度が約1.5倍となることを確認しています。
これにより、段ボールベッドなどの耐久性向上に寄与します。
また、撥水性により湿気による段ボールの劣化を抑えることができます。
さらに、青森ヒバ由来成分「ヒノキチオール」を含有しており、第三者試験にて空間中のカビに対する抑制効果が確認されています。
清潔な環境づくりをサポートする設計です。
【使用方法】
スプレー塗布または刷毛塗りが可能です。
目安として、段ボール片面 1m² あたり 100〜150g の使用量を推奨します。
¥46,200
【保管条件】
・火気の近くを避けて保管してください。
・直射日光・高温多湿を避けて保管してください。
・乳児・お子さま・ペットの手の届かない場所で保管してください。
【使用上の注意】
・本来の用途以外には使用しないでください。
・ 飲料ではありません。誤飲した場合はすぐに医師の診察を受けてください。
・目に入らないようご注意ください。目に入った場合は、直ちに水でよく洗い流し、異物感や異常が残る場合は専門医にご相談ください。
・ 肌に直接使用しないでください。
・猫や小動物のいる環境では使用しないで下さい。
・ 火気には十分ご注意ください。
・換気の良い場所でご使用下さい。